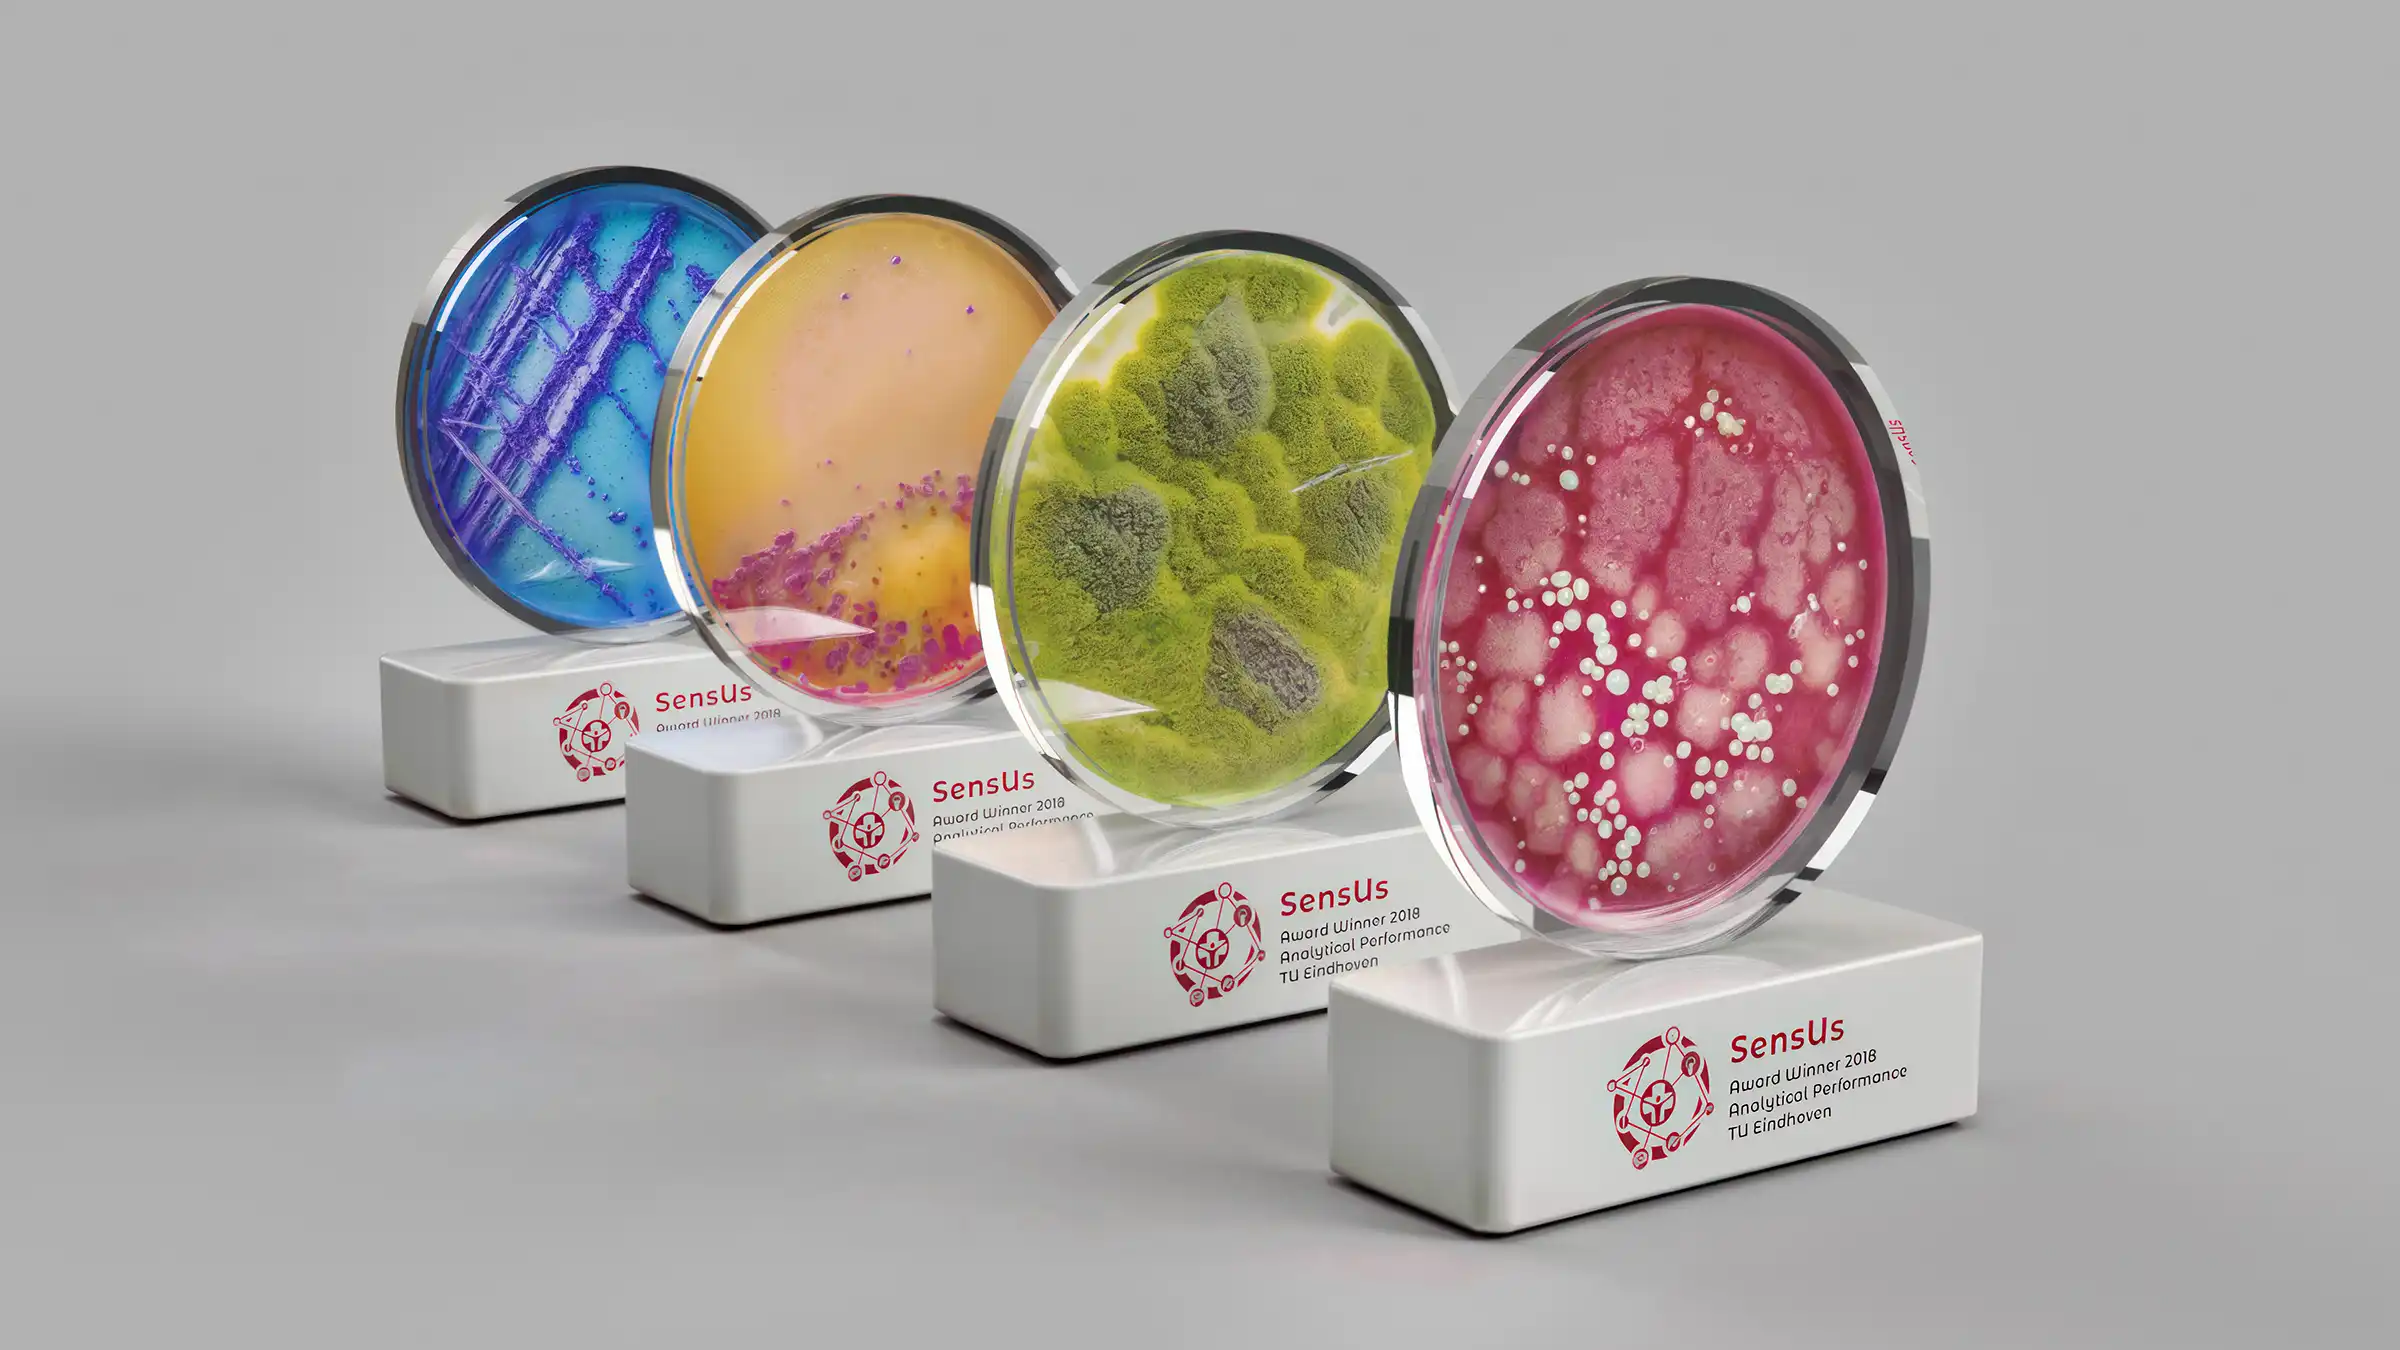
3D award design geïnspireerd op bacterieculturen in petrischaal

recent werk
In dit portfolio vind je een selectie van projecten uit verschillende disciplines, waaronder grafisch ontwerp, branding, architectuur- en vastgoedvisualisaties, productvisualisaties, motion design en ruimtelijk ontwerp. Bekijk ze per type of sector.
VDH
Inplanting en tuinontwerp voor villa in de Vlaamse Ardennen
3D visualisatie voor villabouw op heuvelterrein
Private Client
Ontwerp voor design lamp
Product Design voor deze minimalistische tafel- of boekplank lamp
Saturna Corporates
3D visualisatie vastgoed gevel
Architectuurvisualisatie van renovatieproject in Borgerhout
Saturna Corporates
Interieur visualisaties vastgoed
3D Interieurvisualisaties voor een renovatieproject
Saturna Corporates
3D visualisaties renovatie project Oudenaarde
Visualisatie van renovatie oud postgebouw in Oudenaarde
Isosell
Visualisatie koelcel interieur/exterieur
Visualisatie van industriële elementen rond koelcellen
Scholengroep Sint-Michiel
Campagnebeeld voor lokale scholengroep
Concept campagnebeeld voor lokale scholengroep
BarManiaPro
Flyer voor outdoor beweegtoestel
Flyer ontwerp voor calisthenics en outdoor fitness toestel
Heemkring Molenstede
Karakterdesign heemkring Molenstede
Karakterdesign geïnspireerd op historisch erfgoed
Ondernemerscentra West-Vlaanderen
Week van de Smaak
Animatie 'tv-spot' voor publieksactie rond Week van de Smaak
Enso Visual Design bundelt in dit portfolio een selectie van projecten binnen 3D visualisaties, product design en branding. Van architectuur en vastgoed tot productontwikkeling en visuele campagnes: elk project toont hoe ideeën vertaald worden naar heldere en overtuigende beelden. Actief vanuit West-Vlaanderen werken we voor bedrijven, overheden en creatieve partners in België en daarbuiten.